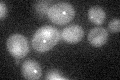
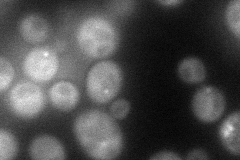
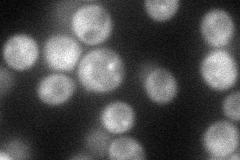
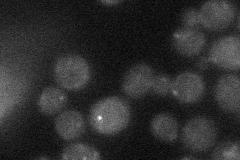
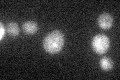

View description
Autophagy-specific protein that is required for recruitment of other ATG proteins to the pre-autophagosomal structure (PAS); interacts with Atg17p and localizas to the PAS in a manner interdependent with Atg17p and Cis1p; not conserved
Localization:
Intensity:
Fold change:
Significance:
-
C’ GFP library in SD
punctate23.54 -
N' NOP1pr-GFP in SD
cytosol,punctate74.8285 -
N' TEF2pr-mCherry in SD
cytosol,punctate57.4235 -
N' NATIVEpr-GFP in SD
punctate23.7443 -
N' TEF2pr-VC and Cyto-VN in SD

cytosol28.7835 -
C’ GFP library in SD+DTT

punctate27.551.17No -
C’ GFP library in SD+H2O2

punctate17.340.73Yes -
C’ GFP library in Starvation Media
punctate28.491.21No -
C’ GFP library on the background of Pup2-DaMP

punctate -
C’ GFP library on the background of CCT mutant

punctate22.23870.944363No
